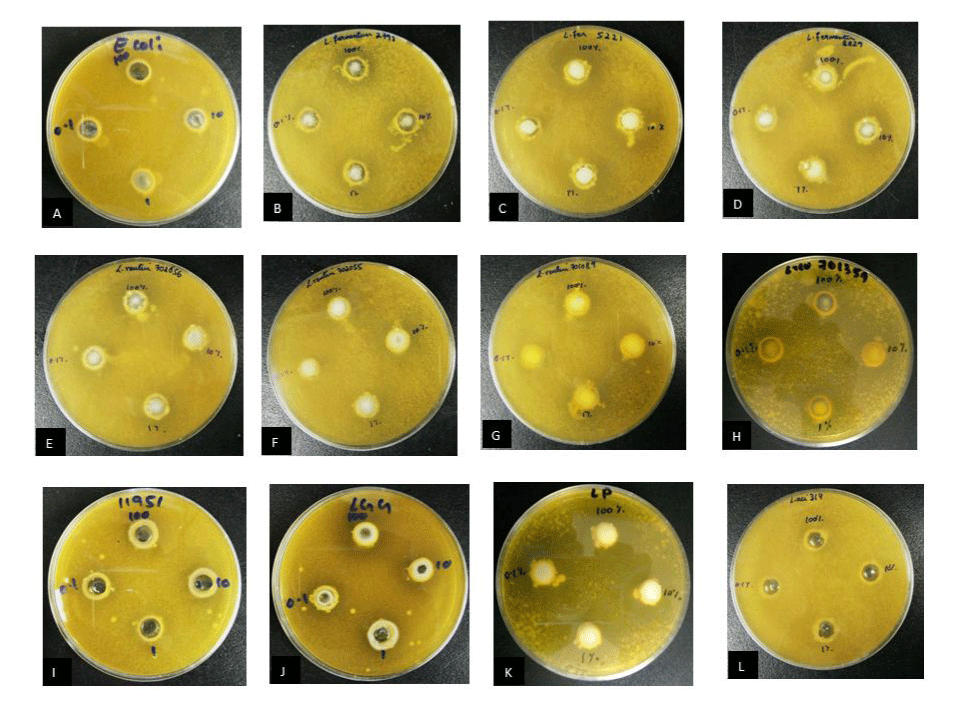

|
| Figure 2: Inhibition assay for C. albicans ATCC 11006 demonstrating the zone of inhibition around the wells containing: (A) Negative Control –E. coli ATCC 8739; (B) Test strain L. fermentum NCIMB 8829; (C) Test strain L. fermentum NCIMB 2797; (D) Test strain L. fermentum NCIMB 5221; (E) Test strain L. reuteri NCIMB 701089; (F) Test strain L. reuteri NCIMB 701359; (G) Test strain L. reuteri NCIMB 702655; (H) Test strain L. reuteri NCIMB 702656; (I) Test strain L. reuteri NCIMB 11951; (J) Positive control- L. rhamnosus ATCC 53103; (K) Test strain L. acidophilus ATCC 314; (L) Test strain L. plantarum ATCC 14917 and *shows the clearance zone. The four wells contained the probiotic overnight culture of desired concentration diluted using sterile MRS: 100% (v/v), 10% (v/v), 1% (v/v) and 0.1% (v/v). The agar plates were incubated for 48 hours at 37°C and 5% CO2. |